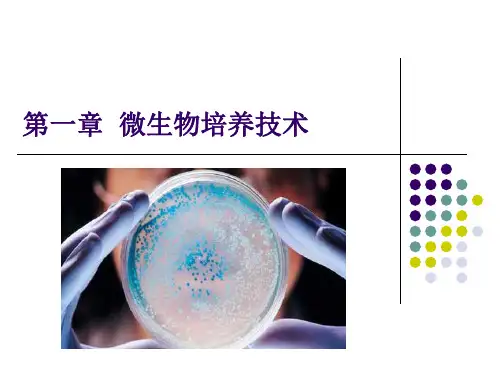

第一章微生物的分离和纯培养hw
- 格式:ppt
- 大小:6.18 MB
- 文档页数:56






第一节微生物的分离和纯培养一、培养基1.含义由于微生物代谢方式的不同,因而对营养物质的需求也是有差异的。
根据微生物生长繁殖和代谢的需要,将各种营养物质混合在一起而配制的营养基质。
2.平板培养基将溶化后的固体培养基基质倒入无菌培养皿中,冷却凝固后制成的培养基。
二、无菌技术1.目的和要求在微生物的分离和纯培养中,一定不能有外来的污染性杂菌,所以必须采用无菌技术进行操作。
因此,在实验过程中,要对所用的器材、培养基进行严格的灭菌,对工作场所要进行消毒。
2.灭菌和消毒(1)灭菌:用强烈的理化因素杀死环境或物体内外所有的微生物,常用的方法是高温灭菌法。
(2)消毒:用相对温和的理化方法杀死环境或物体上的病原微生物和有害微生物的营养细胞,常用的方法是射线消毒法和化学药剂消毒法。
三、接种技术1.含义把相应的研究对象移入培养基中的过程。
2.分类在平板培养基上接种的方法有平板划线法、稀释平板涂布法、稀释混合平板法等。
预习完成后,请把你认为难以解决的问题记录在下面的表格中问题1问题2问题3问题4一、微生物的概念及特点1.概念微生物是一切肉眼看不见或看不清楚的微小生物的总称。
2.特点微生物Error!微生物Error!二、微生物的营养及功能微生物的化学组成成分与其他生物大体相同,也是由C、H、O、N、P、S等元素组成,其中C、H、O、N占细胞干重的90%以上,这些元素最终来自外界环境中的各种无机化合物和有机化合物。
这些化合物可归纳成碳源、氮源、生长因子、无机盐和水这五大类营养要素。
营养物质定义作用主要来源碳源凡能提供所需碳元素的物质构成生物体的细胞物质和一些代谢产物,有些是异养生物的能源物质无机化合物:CO2、NaHCO3等;有机化合物:糖类、脂肪酸、花生粉饼、石油等氮源凡能提供所需氮元素的物质合成蛋白质、核酸以及含氮的代谢产物无机化合物:N2、NH3、铵盐、硝酸盐;有机化合物:尿素、牛肉膏、蛋白胨等生长因子生长必不可少的微量有机物酶和核酸的组成成分维生素、氨基酸、碱基等水在生物体内含量很高,在低等生物体内含量更高不仅是优良的溶剂而且可维持生物大分子结构的稳定外界摄入无机盐 为微生物提供除碳、氮以外的各种重要元素,包括大量元素细胞内的组成成分,生理调节物质,某些化能自养菌的能源,酶的激活剂无机化合物①微生物最常利用的碳源是糖类,尤其是葡萄糖;最常利用的氮源是铵盐、硝酸盐。

中图版选修1高一生物第一章第1节课件:微生物
的分离和纯培养
导读:本文中图版选修1高一生物第一章第1节课件:微生物的分离和纯培养,仅供参考,如果觉得很不错,欢迎点评和分享。
中图版选修1第一章第1节《微生物的分离和纯培养》ppt学习导航
1.了解有关微生物及其培养基的基础知识。
2.理解消毒和灭菌的原理、方法、进行无菌技术的操作。
[重点]
3.理解微生物接种的方法步骤,进行大肠杆菌的分离和纯培养。
[重、难点]
一、培养基
1.含义:由于微生物代谢方式的不同,因而对营养物质的需求也是有差异的。
根据微生物_________________的需要,将各种营养物质混合在一起,配制成适合微生物生存的营养基质。
本站课件均从网络收集或是会员上传,版权归原作者所有,请大家尊重作者的劳动成果,并积极上传自己的作品与大家一起分享交流,帮助别人就是帮助自己!
普通下载。